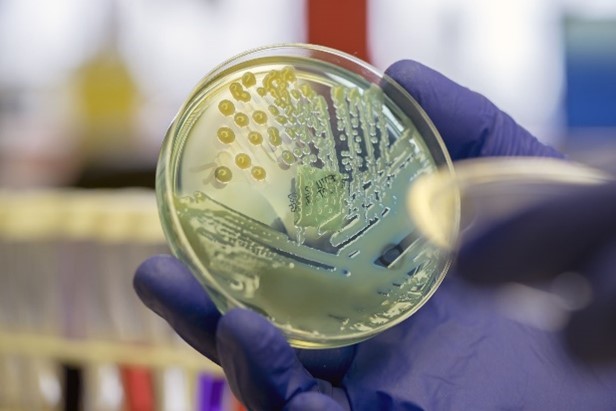

Welcome to our new website!
Legionella Risk Assessment


The Approved Code of Practice L8 (see link) details the requirement to carry out an identification and assessment of the risk of exposure to legionella bacteria. It is generally understood and accepted that a specific legionella risk assessment needs to be in place for a premises and it needs to be reviewed regularly or when certain factors come into play. But what else can the document do for us?
Troubleshooting sample results
One thing we commonly see in the field is how often people react incorrectly when a water sample result comes back showing out of specification levels. HSG 274 Pt.2 (see link) clearly details that the risk assessment should be reviewed following “the results of checks indicating that control measures are no longer effective.” Referring to the risk assessment when something goes wrong is a useful tool in helping us to work out why the failure has occurred. Few refer to the risk assessment if they receive an out of specification result, and that behaviour should change.
Visualising the water system
As well as ticking all the boxes for compliance, the risk assessment can provide a useful guide to how our water systems work. Any decent assessment will contain photographs of the plant and other items of interest and can remove the need for the user having to physically go to specific areas to get an overview.

The assessment should also contain a schematic diagram of the system. As well as showing that the assessor has understood the system, the schematic diagram can provide an excellent point of reference for someone who is not familiar with the system or doesn’t have any specialised training or experience. Perhaps the most famous example of an effective schematic drawing is the map of the London Underground system. This map isn’t geographically or technically correct, but it does give you an instant answer as to whether you can change from the Central line to the Piccadilly line at Holborn!
A living document
To manage systems effectively, the assessment must remain up to date. It should be a living document, with amendments made as people, systems, new technology and the building use change. Again, most assessments we are asked to review aren’t living, but when they are it makes the management of the system so much easier.

Can we help you?
Managed Water Services Ltd are constantly striving to improve their legionella risk assessment offering. If this is something that you want to grip this year, then please get in touch with us and we can talk through your needs and work out the solution that works best for you and your business.
t: 01422 208 518 (North)
t: 01245 362 366 (South)

Trusted water safety built on over 60 years of expertise.
Registered Office | 1st Floor, 11 Freeport Office Village, Century Drive, Braintree, Essex, CM77 8YG.
Registered in England and Wales | No: 05623756.
